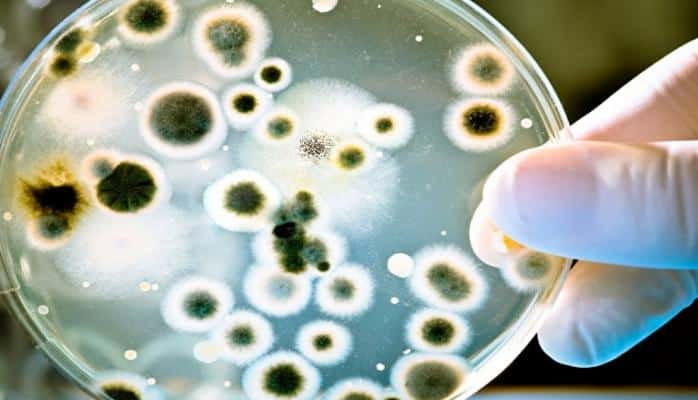
Ученые выяснили, как распространяются устойчивые к лекарствам бактерии

Автор: Leyla Tagiyeva
Автор: Leyla Tagiyeva